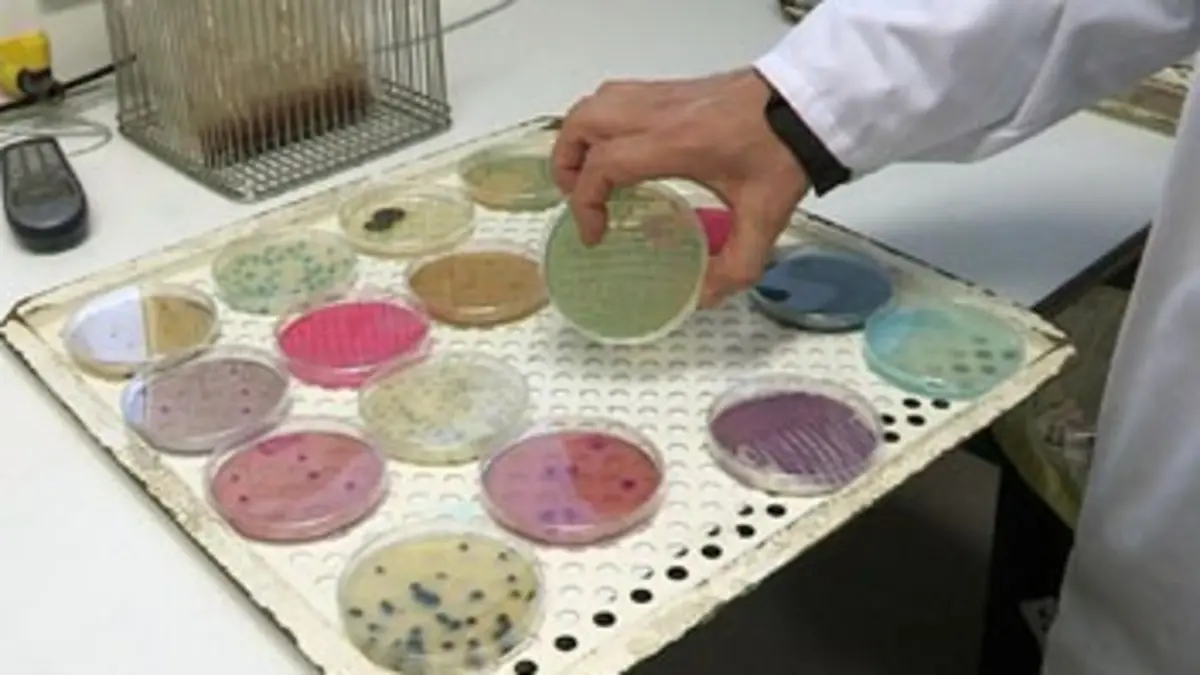
La sécurité alimentaire

Chaque jour, des produits de consommation courante sont retirés en urgence des rayons par les autorités sanitaires, qui les jugent suspects ou dangereux à la consommation. Des alertes sont lancées quotidiennement à l'échelle européenne. Et les aliments bio ne sont pas épargnés par ces scandales, comme l'a montré l'affaire des graines germées en Allemagne, contaminées par l'escherichia coli. En cause bien souvent, l'importation de composants produits dans des pays où les contrôles s'avèrent difficiles, et où les normes européennes ne s'appliquent pas, comme en Chine. Enquête sur les filières d'approvisionnement de l'industrie agroalimentaire, en compagnie d'experts qui veillent à la sécurité des consommateurs, surpris de trouver du colorant industriel dans certains antibiotiques et des salmonelles dans la charcuterie.